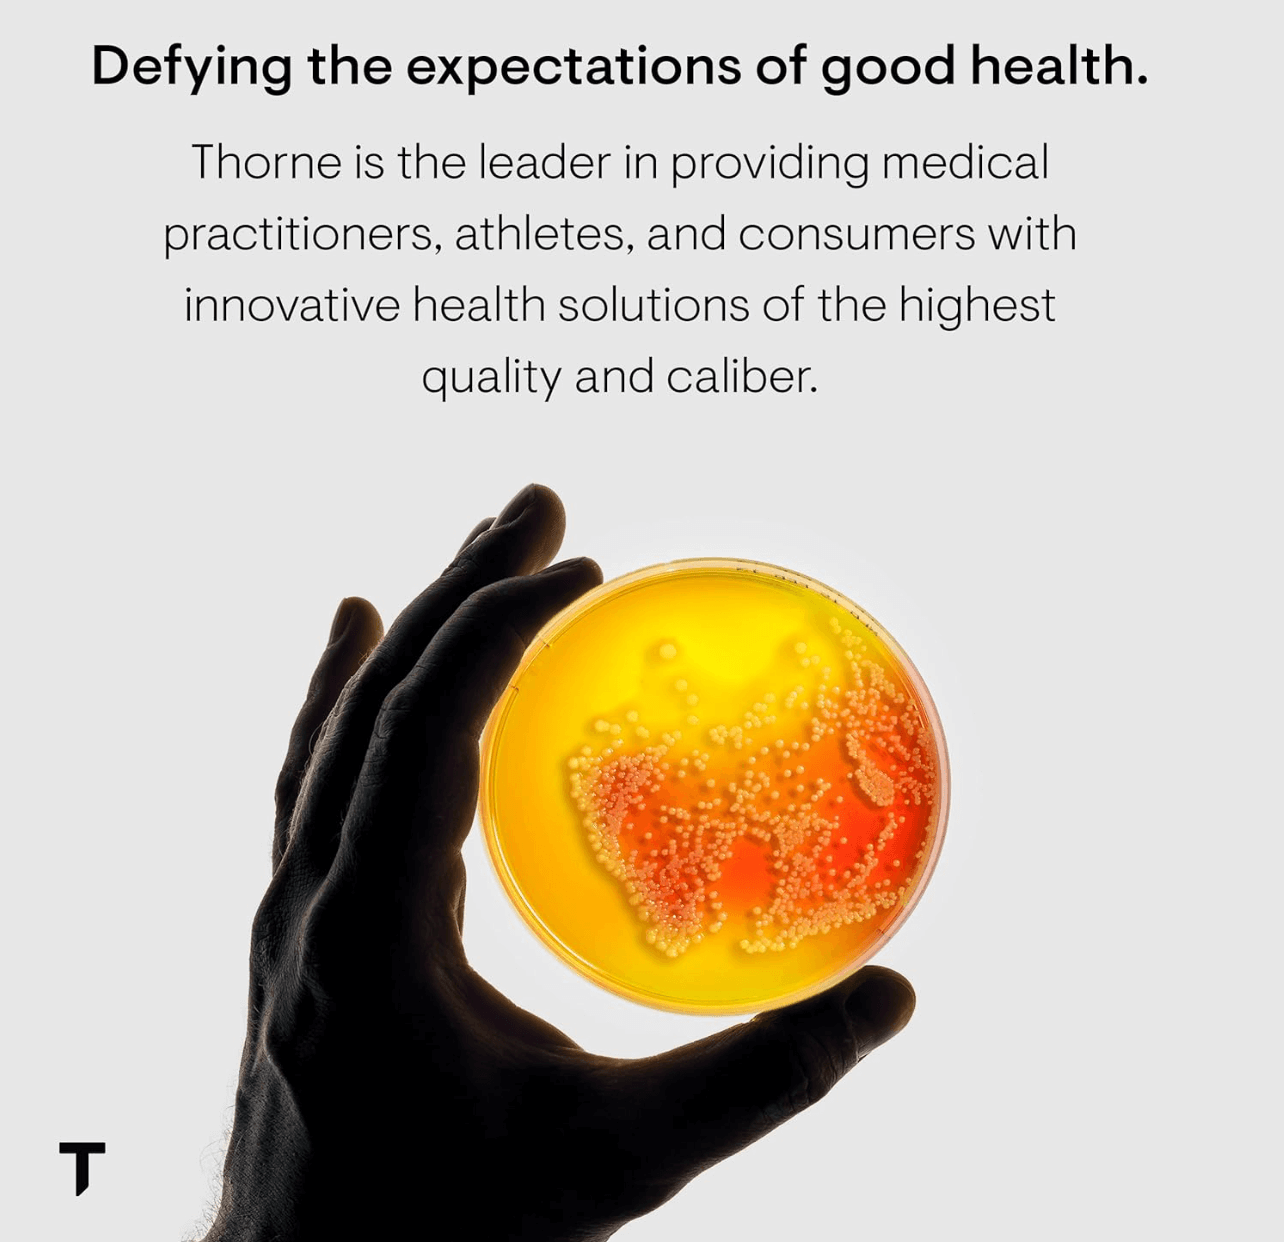

- Overview
- Ingredients
- Shipping
- Returns
- About the Brand
An advanced antioxidant formula made from broccoli seeds for long-lasting cell protection*
Crucera-SGS offers the chemo-protective properties of sulforaphane glucosinolate (SGS) to provide cells with long-lasting protection from free radical damage and to support liver detoxification.*
Sulforaphane glucosinolate (SGS) is a natural substance extracted from the seeds and sprouts of select broccoli varietals. It is an indirect antioxidant that provides long-lasting cell protection from free radical damage.* Typical antioxidants, such as vitamin C, vitamin E, and beta carotene, work "directly" to neutralize free radicals and are usually effective for only approximately three hours after ingestion.* When Thorne's Crucera-SGS is ingested and begins to break down in the gut, it releases sulforaphane, thereby activating the body's natural detoxification and antioxidant enzymes and providing protection to cells from free radical damage for several days.* Each capsule of Thorne's Crucera-SGS is equivalent to eating two pounds of cooked broccoli.*
Sulforaphane was first identified in 1992 by researchers at Johns Hopkins University School of Medicine and is now believed to be the key component of many of the health benefits attributed to cruciferous vegetables, such as broccoli, cabbage, cauliflower, and kale.* Research on sulforaphane has produced more than 500 journal articles over the past two decades.
- An indirect antioxidant that provides long-lasting cell protection (targeted chemoprotection) from free radical damage for days after being consumed
- Activates the body's natural detoxification enzymes
- SGS identified in 1992 by researchers at Johns Hopkins University School of Medicine
- SGS thought to be the key factor behind the many health benefits attributed to cruciferous vegetables, including broccoli
- Thorne products contain ingredients from the purest sources worldwide. Flavors, colors, preservatives, and sweeteners are derived from natural sources. Our products never contain gluten, Genetically Modified Organisms (known as GMOs), artificial preservatives, stearates, wheat, rye, barley, eggs, or nuts. This product does not contain dairy, soy, corn, sugar, or magnesium stearate
This is a statement of nutritional support. This statement has not been evaluated by the Food & Drug Administration. This product is not intended to diagnose, treat, cure or prevent any diseases. Individual results may vary
General Shipping Information
Orders over $75 ship FREE with Standard Shipping
Orders must total $75 before tax (and after any promotional discounts) to qualify. We do not ship internationally at this time.
In most cases, we are able to ship orders placed before 1:00 pm central time on the same day.
Estimated delivery time: 3-5 business days.
Pick Up Orders: pick-up orders placed before 2:00 are generally ready same day. However, we will contact you when the products are ready for pick up in our Bee Cave Alive + Well Store.
Texas Orders: local Austin orders are generally delivered next business day - without any additional fees. Most major Texas cities are also eligible for next business day delivery (call to learn if your city is eligible for next day delivery)
USPS Priority Shipping
Estimated delivery time: 3-5 business days.
2-Day and Overnight: Order must be placed by 12pm CST for processing on same day. Orders placed after 12pm CST on Thursday will ship on Friday and will be delivered on the following Monday (via Overnight) or Tuesday (via 2-Day). Orders placed after 12pm on Friday will ship on the following Monday. 2-Day and Overnight orders cannot be delivered on Saturdays or federal holidays. Not available for delivery to PO Boxes.
Standard Shipping: Orders shipped via standard shipping may be delivered to PO Boxes and APO/FPO/DPO addresses. Shipping carrier and method will be determined by Alive + Well's Shipping Department. Standard shipping time is 3-5 business days.
Shipments outside the continental US: 2-Day and Overnight shipping orders to Alaska and Hawaii are subject to an additional charge of $10.
Shipments to Puerto Rico can only be done via USPS; 2-Day and Overnight shipping options are not available.
Shipping Refrigerated Products : Our manufacturers formulate their probiotics to ensure their products retain viability until they reach the consumer. Probiotics that are recommended to be refrigerated remain so until the time of shipment, then shipped alongside an ice pack to ensure potency (Note: Ice pack will not arrive frozen, and product may not arrive cold). However, you may want to consider using 2-Day and Overnight shipping methods when purchasing probiotics to ensure maximum potency.
Orders placed on a Thursday-Sunday requiring cold shipping will not ship until the following Monday.
Shipping Address: A safe and accurate address for delivery must be provided at the time the order is placed. Once an order has shipped, Alive + Well is not responsible for lost or stolen packages confirmed to be delivered to the address as entered for the order. If the tracking indicates the package has been delivered, you would be required to place a new order.
AUTOSHIP ORDERS
When you subscribe for Autoship, you'll save 10% on future automatic order (select products do not include a discount on recurring orders). You can skip an order, change the frequency, pause your subscription, or cancel at any time. Your credit card will be billed and the order will be shipped on the same day the order is set to process. You can update your Autoship schedule or make any changes to the order in your online account. You can cancel this schedule at any time.
Additional discounts cannot be applied to autoship products.
Shopping is risk-free with our 30-day return guarantee*. If for any reason you are not satisfied with your purchase, simply send the unused portion back to Alive and Well within 30 days of purchase. Return postage is the responsibility of the customer. You will receive a full refund for the item(s) in the original form of payment. After we process your return, it may take several business days for the refund to appear on your credit card, depending on your financial institution.
*Select products are final sale.
Please note that we are only able to process returns for a maximum of 3 items per year.
Shipping and handling charges are non-refundable. For returns via mail, the product must include your full name, order number and be carefully packaged. Return postage is the responsibility of the customer.
Once your return has been received, a refund will be issued within 14 days in the original form of payment, and an email confirmation will be sent.
Please return shipments to the following address:
Alive + Well Returns3944 Ranch Road 620Bldg 8, Ste 100Bee Cave, TX 78738